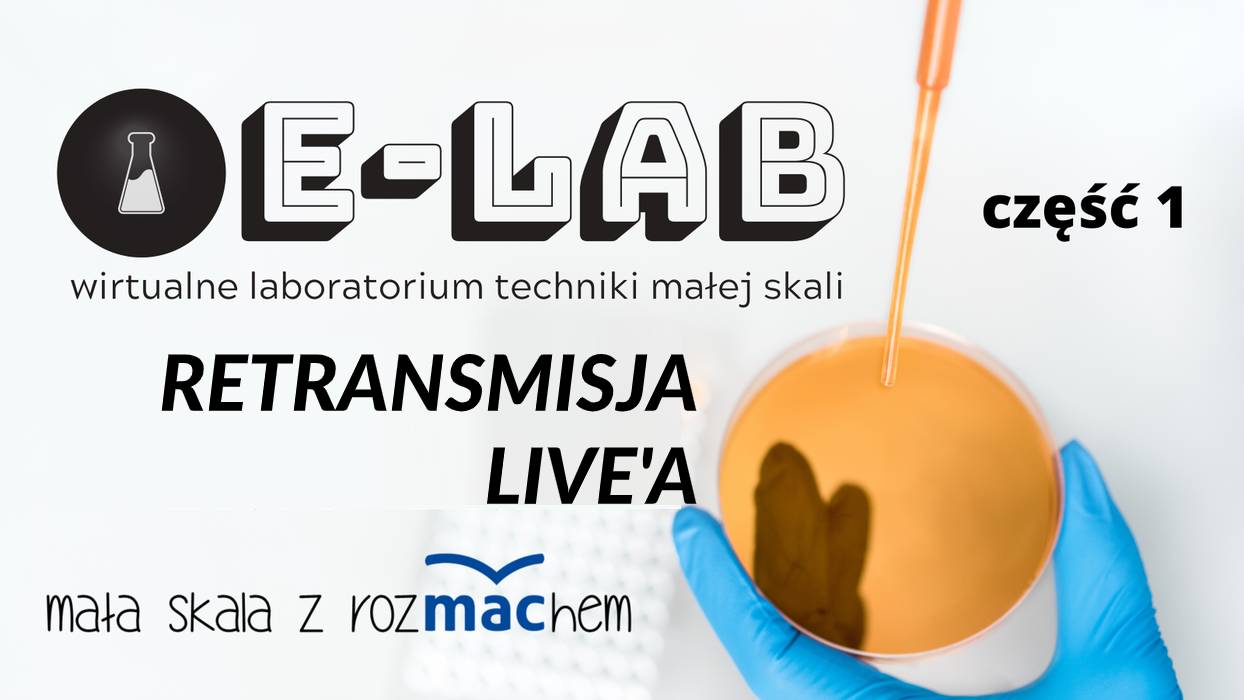
thumbnail.jpg

Szkoła podstawowa
Wiedza daje bezpieczeństwo! Edukacja dla bezpieczeństwa w szkole podstawowej
04 / 03 / 2021 | 12:00
E-konferencje
 E-konferencje
E-konferencje
Szkoła podstawowa
Samorząd terytorialny, władza ustawodawcza, prawa człowieka – to niezmiennie ważne terminy. W e-konferencji porozmawiamy o tym,...
Jak ciekawie nauczać WOS w szkole podstawowej?
02 / 03 / 2021 | 10:00
Agata Gołaj
 E-konferencje
E-konferencje
Szkoła podstawowa
Agresor, pasożyt, chwalipięta, pesymista, dominator – to przykłady niebezpiecznych osobowości, z którymi możemy spotkać...
Niebezpieczne osobowości. Jak rozpoznać i radzić sobie z trudnymi relacjami w życiu zawodowym
18 / 02 / 2021 | 09:00
Dorota Nowocień
 E-konferencje
E-konferencje
Szkoła podstawowa
Zdalne nauczanie na dobre zagościło w naszych domach. Dzisiaj wspólnie z naszym gościem – panią Dorotą Nowocień –...
Nauczyciel wobec wyzwań edukacji w świecie on-line
19 / 11 / 2020 | 00:00
Dorota Nowocień
 E-konferencje
E-konferencje
Szkoła podstawowa
„Cyfrowi tubylcy” – to pojęcie oznaczające ludzi urodzonych w czasach powszechnego stosowania w życiu codziennym:...
Czas i przestrzeń w procesie nauczania historii pokolenia „cyfrowych tubylców"
29 / 04 / 2020 | 00:00
 E-konferencje
E-konferencje
Szkoła podstawowa
Dziecko w klasie jest nie tylko uczniem, ale przede wszystkim człowiekiem. Ma swoje pasje, problemy, doświadczenia. Chce być dostrzeżone...
"Halo, czy ktoś mnie słyszy? - rola relacji w nauczaniu w szkole podstawowej"
23 / 04 / 2020 | 08:00
Dorota Zawadzka
 E-konferencje
E-konferencje
Szkoła podstawowa
Laptopy, tablety czy dostęp do sieci? Co będą mogły kupić samorządy, by wspierać nauczycieli i uczniów.
Jak będzie...
Program #zdalnaszkoła. 186 MLN ZŁ NA WALKĘ Z WYKLUCZENIEM CYFROWYM UCZNIÓW
01 / 04 / 2020 | 15:00
Roman Lorens
E-konferencje
E-konferencje
Szkoła podstawowa
Transmisja odbyła się 25 marca 2020 r. o godz:20:00 na FanPage'u "Centrum Chemii w Małej Skali" na Facebooku.
Poczuj nie...
[RETRANSMISJA] Chemia w małej skali - cz.1
25 / 03 / 2020 | 20:00
 E-konferencje
E-konferencje
Szkoła podstawowa
Koncepcja serii Plastyka pod względem rozkładu treści nauczania oparta jest – zgodnie z nową podstawą programową – na...
O nauczaniu plastyki na nowo
20 / 03 / 2020 | 15:00
Marzena Kwiecień
 E-konferencje
E-konferencje
Szkoła podstawowa
Jak przeprowadzić interesujące zajęcia z przyrody w klasie 4 szkoły podstawowej? Który podręcznik wybrać? Jakie zmiany czekają...
Lekcje przyrody nie muszą być nudne
20 / 03 / 2020 | 15:00
prof. dr hab. Ilona Żeber-Dzikowska